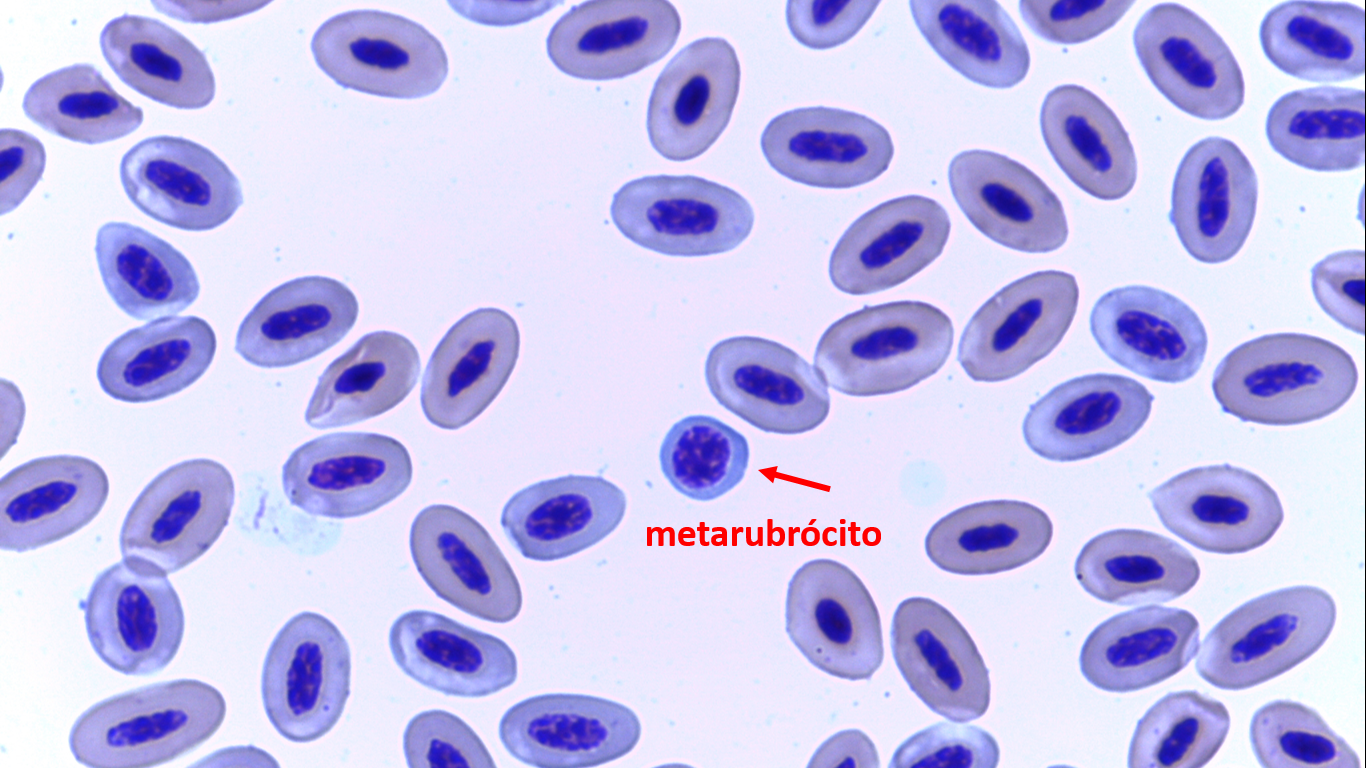
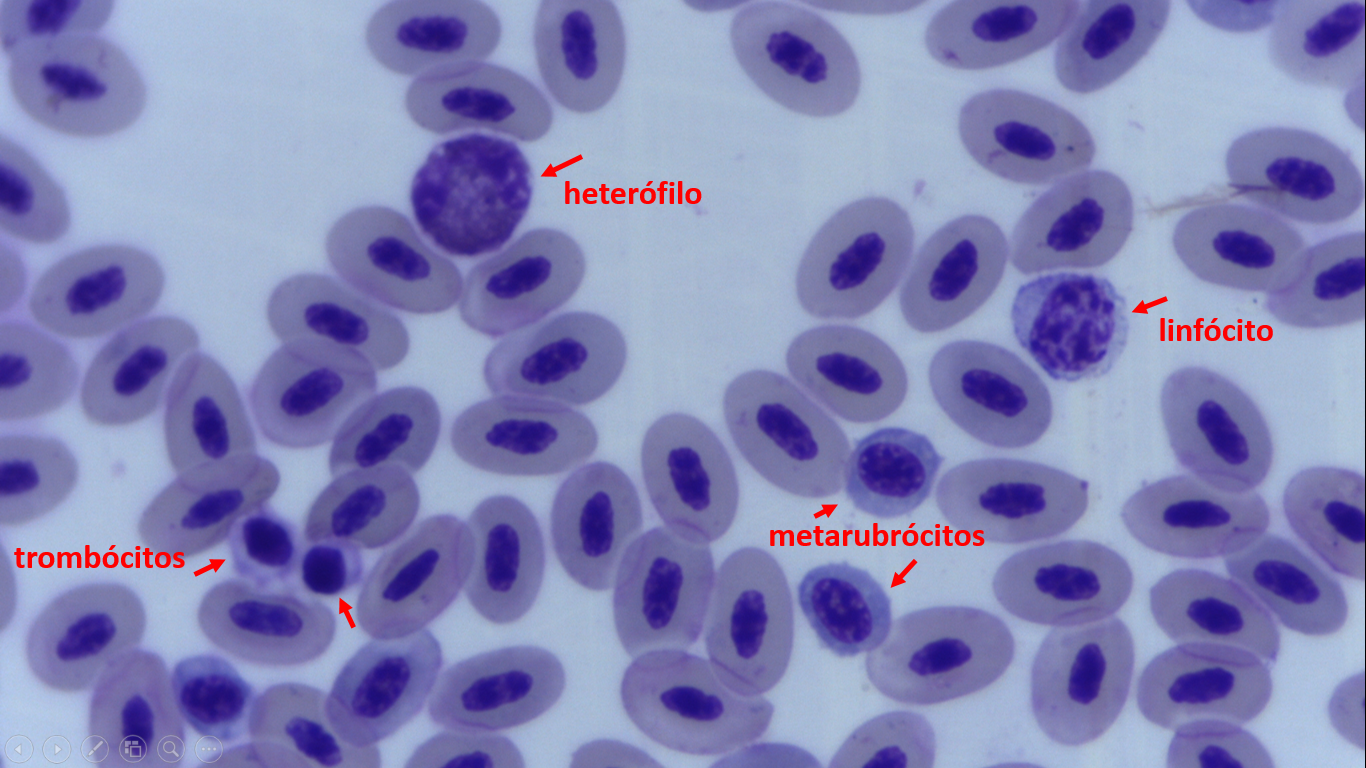

Eritrócitos
01) Sangue periférico de carcará (Caracara plancus). Eritrócitos maduros, normais e dois eritrócitos policromatófilos (setas). Coloração de Wright (100x).
02) Sangue periférico de avestruz (Struthio camelus). Eritrócitos maduros e um eritrócito policromatófilo (seta). Coloração de Wright (100x).
03) Sangue periférico de avestruz (Struthio camelus). Eritrócitos maduros e um metarubrócito (seta). Coloração de Wright (100x).
04) Sangue periférico de cardeal amarelo (Gubernatrix cristata). Eritrócitos maduros, um heterófilo (seta) e trombócito (tromb). Coloração de Wright (100x).
05) Sangue periférico de coruja do mato (Strix virgata). Eritrócitos maduros, eritrócitos policromatófilos, com citoplasma azul (setas) e célula rompida. Coloração de Wright (100x).
06) Sangue periférico de cardeal amarelo (Gubernatrix cristata). Eritrócitos maduros, vários eritrócitos policromatófilos (forma elíptica, com citoplasma azul) e um metarubrócito (eritrócito precursor, forma esférica e citoplasma azul). Coloração de Wright (100x).
07) Sangue periférico de cardeal amarelo (Gubernatrix cristata). Eritrócitos maduros, vários eritrócitos policromatófilos (Er Pol) e uma célula em mitose. Coloração de Wright (100x).
08) Sangue periférico de coruja do mato (Strix virgata). Eritrócitos maduros e um eritrócito imaturo (metarubrócito). Coloração de Wright (100x).
09) Sangue periférico de papagaio. Eritrócitos maduros e um eritrócito imaturo (metarubrócito). Coloração de Wright (100x).
10) Sangue periférico de papagaio de cara roxa de vida livre (Amazona brasiliensis). Eritrócitos normais, eritrócitos hipocromicos (citoplasma pálido), um heterófilo, um linfócito e trombócito. Coloração de Wright (100x).
11) Quatro tipos de reticulócitos da arara canindé (Ara ararauna). (A) reticulócito pontilhado 1 (centro, seta): com < 10 pontos de retículo corado; à direita um reticulócito em anel (t); lado inferior esquerdo um reticulócito agregado (k); acima um reticulócito pontilhado 1 (z); (B) reticulócito pontilhado 2 (no centro, seta): com ≥ 10 pontos de retículo corado; abaixo dois reticulócitos pontilhados 1; (C) reticulócito agregado (no centro, seta): com agregados de retículo corado difuso no citoplasma; dois reticulócitos em anel (x); três reticulócitos pontilhado 1 (y); (D) reticulócito em anel (no centro, seta): reticulócito com agregado de retículo corado em forma de anel, contínuo ou não, em pelo menos metade do núcleo; acima quatro reticulócitos do tipo pontilhado 1. Coloração: Azul de Cresil Brilhante, contra corado com Wright (100x)
12) Sangue periférico de papagaio de cara roxa de vida livre (Amazona brasiliensis). Eritrócitos normais, metarubrócitos, heterófilo, linfócito e trombócito. Coloração de Wright (100x).
13) Sangue periférico de pinguim (Spheniscus magellanicus). Eritrócitos maduros, com citoplasma laranja e núcleo central com cromatina condensada. Eritrócitos policromatófilos (Eritr Pol) com citoplasma basofílico (azul). Coloração de Wright (100x).